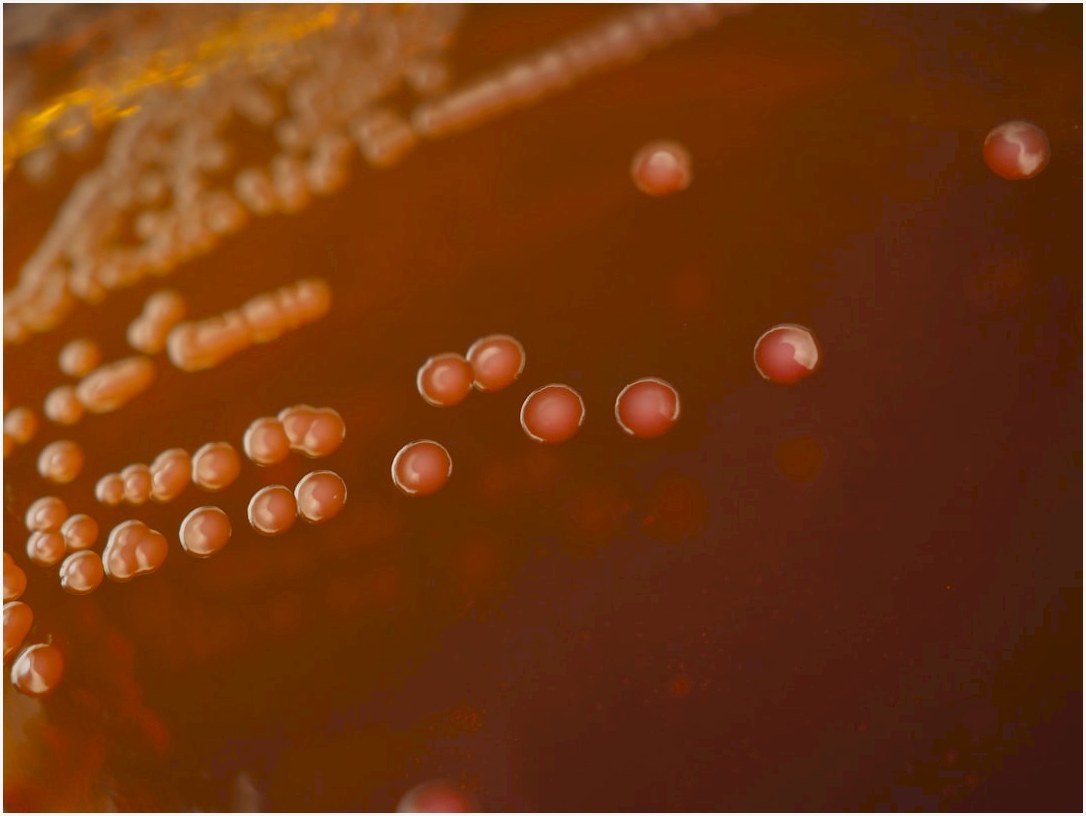
a close up of a bunch of pills on a table

Revolução na Agronomia: Descoberta Brasileira Pode Triplicar Safra de Soja e Agita o Agro em 2024
Produtores no Piauão relatam aumento de até três vezes na produtividade da soja após aplicar um bioinsumo desenvolvido por pesquisadores da Universidade Federal do Piauí. Essa Revolção na Agronomia brasileira, baseada em uma nova cepa de bactéria fixadora de nitrogênio isolada em solos do Matopiba, já chama atenção de cooperativas no Centro-Oeste e até de empresas estrangeiras.
Os testes preliminares, divulgados em fórum da Embrapa no início de 2024, mostram ganhos expressivos em áreas com baixa fertilidade. Ruralistas que adotaram o produto viram sacas por hectare saltarem de 25 para mais de 70, dependendo do manejo integrado.

O que move essa Revolução na Agronomia
A cepa em questão, batizada informalmente de Piauiense-1, é um rizóbio otimizado que coloniza as raízes da soja com maior eficácia. Diferente dos inoculantes tradicionais, ela resiste melhor à seca inicial e libera nitrogênio de forma prolongada, reduzindo a necessidade de adubos químicos em até 40% segundo relatos da UFPI.
Estudos publicados no Journal of Applied Microbiology confirmam potencial similar em outros países, mas o isolamento local adapta o microrganismo ao clima tropical brasileiro. Quem planta no Cerrado, por exemplo, nota que o bioinsumo complementa variedades como BRS 1003 Pro, elevando rendimentos sem elevar custos fixos.
Testes de campo espalham o impacto pelo país
No Maranhão, cooperados da Copama testaram o produto em 200 hectares na safras 2023/24 e registraram 85 sacas por hectare em média, contra 45 nas áreas padrão. O volume extra cobriu margens apertadas pela alta nos insumos e ainda gerou sobras para venda antecipada.
Em Bahía, um agricultor de Luiz Eduardo Magalhães compartilhou no YouTube, no canal AgroBahia, como passou de 35 para 105 sacas por hectare combinando o inoculante com plantio direto otimizado. Esse caso viralizou entre técnicos, mostrando que o ganho vem da simbiose aprimorada entre planta e solo.
A Revolução na Agronomia ganha força com dados da Conab, que apontam produtividade nacional em 67 sacas por hectare na última safras, mas com picos acima de 100 em regiões pioneiras. O novo bioinsumo abre caminho para quebrar esses limites em biomas como Caatinga e Amazônia.
Como o setor reage à novidade
Cooperativas como a Coamo no Paraná já negociam parcerias para multiplicar a cepa em escala comercial. O aporte inicial, estimado em R$ 2 milhões pela Finep, acelera a validação em mais de 10 mil hectares até o fim do ano.
Empresas de defensivos, atentas ao movimento, integram o produto em pacotes de manejo, reduzindo riscos de perdas por ferrugem. Para o produtor, isso significa menos passes de pulverização e mais foco na colheita, especialmente em anos de La Niña.
Desafios e próximos passos na prática
Ainda em fase experimental, a cepa exige calibração por região para evitar variações em solos argilosos do Sul. Técnicos da Emater recomendam misturar com fungicidas compatíveis e monitorar pH, garantindo fixação ótima.
No Norte, relatos de cooperativas em Rondônia indicam adaptação rápida à soja safrinha, com potencial para elevar a segunda safra em 50% sem irrigação extra. O crédito rural via Pronaf pode bancar os testes iniciais para pequenos ruralistas.
Essa Revolução na Agronomia reforça o Brasil como líder em biotecnologia agrícola, com olhos no mercado global que busca redução de emissões. Cooperados interessados devem contatar a Embrapa Soja em Londrina ou extensionistas locais para kits experimentais, antes da semeadura da próxima safras.